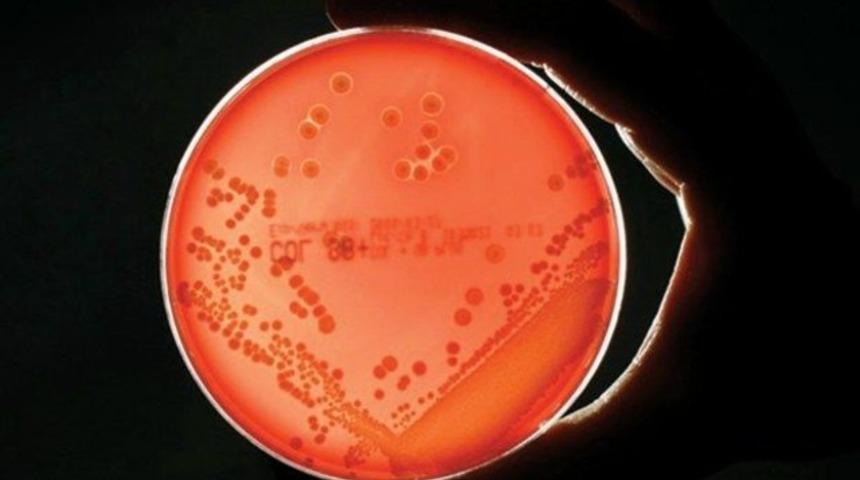
Antibiyotik yerine ‘süper enzim’

‘Staphefekt’ adı verilen enzimin, MRSA isimli süper bakteriyi yenmeyi başardığını açıklayan araştırmacılar, bunun antibiyotiklere direnç gösteren hastalıklarla ilgili önemli bir adım olduğunun altını çizdiler.
Uzmanlara göre, MRSA isimli süper bakterinin, süper enzimle yapılan bu yeni tedaviye karşı da bağışıklık kazanma olasılığı oldukça düşük. Şimdilik sadece cilt enfeksiyonlarına karşı kullanılmak üzere krem formunda piyasaya sürülse de biliminsanları, önümüzdeki 5 yıl içinde bu süper enzimi içeren, antibiyotiklere alternatif bir hap geliştirmeyi planlıyorlar.